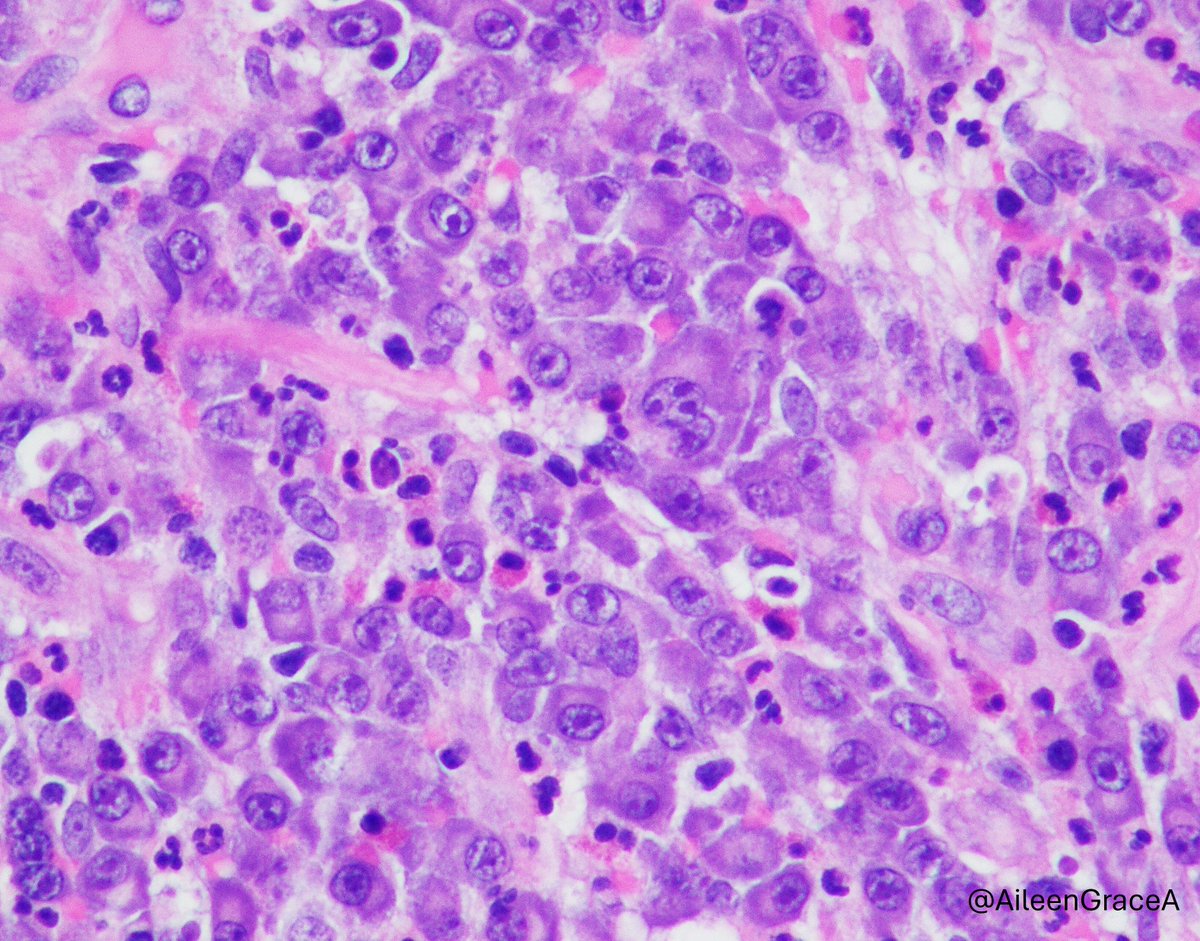
CooperPathology tweet media

basharat mubeen
235 posts

basharat mubeen
@isar4801
Finds beauty in grossly invisible world. (Fellow GI path)
Pulwama Katılım Ocak 2013
191 Takip Edilen147 Takipçiler

7yo with a firm, slowly growing subcutaneous nodule on the upper arm. Present for months, non-tender. Excised.
H&E, 4x and 10x.
What's your diagnosis? 🔬
#PathTwitter #Dermpath #WhatIsYourDiagnosis #MedTwitter


English
basharat mubeen retweetledi

@TataMemorial @TMC_Varanasi @HBCHRCVIZAG @HBCHRC_Punjab @CceTmc @ACTREC_TMC entire TMC family deeply saddened by untimely demise of our alumnus, India’s most illustrious pathologist, Dr Anita Borges. Huge loss to oncology fraternity & patients. Family & friends in our prayers

English

A 60-year-old cisgender man with no medical history underwent colonoscopy, revealing superficial erosions and a “foreign body.” @valensev #path #infectpath #Parasite


English

@Hashimoto__0 @joyfullyshams Dysplasia in overlying epithelium,sarcomatoid scc is definitely a possibility
English

@CooperPathology @navale_pooja @AileenGraceA @UJoneja @RuthBirbe @Gord_Zhu @324Amandeep @Dejan1295208 Plasmablastic lymphoma
English

A rare site in #EndocrinePath
Hx of HyperPTH. Parathyroid gland > 0.5 grams
What's your diagnosis?
#PathX @UMichPath


English

Rectal polypectomy revealing what type of tumor? Answer: buff.ly/RcG5Paq #PathArt #PathTwitter #MedTwitter

English

‘Your heart knows the way. Run in that direction !’
50s/M
Rectal growth
Your thoughts 💭
#PathX #PathTwitter #surgicalpath #oncopath #GIpath #imanpath #pathologist #pathology

English

1/2 #GIpath #BSTpth 20 ish female. Gastric mass. I am sure it is benign but not sure what to call this🤔 @TristanRutland7 @RunjanChetty @_Wondweson64 @ariella8 @DanGrahamMD @Dr_Brian_Cox @DrMarkOng @Dina_hussein94 @drtimbracey @DrRanasaleh @xenaalab @emma_furth @GIJamesMD




English

Why nobody reads the books nowadays. So we have this in sigmoid... booting round...What is its name?
#PathTwitter #gipath @Dr_Brian_Cox @ALBoothMD

English

✨ Pathology is always thrilling!!
When the gross morphology👀speaks volumes, it’s time to investigate.
Think you can pinpoint 🎯
➺ the site?
➺ Diagnosis?
#PathX #Pathresidents #Surgpath #PathTwitter #grossing @Pathologists #GIpath
#path2path

English